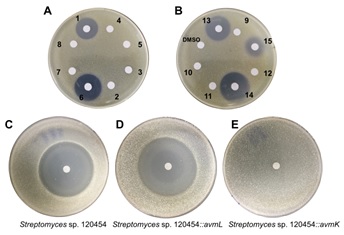

氧化还原修饰是天然产物生物合成中的重要化学过程。这一过程可大大提高天然产物结构的复杂性,提升天然产物的生物活性、增加水溶性等作用。氧化还原修饰是由一系列氧化还原酶所介导的,比如:细胞色素P450、α-酮戊二酸依赖的氧化酶,NAD(P)H/NAD(P)+以及黄素等依赖的氧化还原酶等。这些氧化/还原酶介导的天然产物的化学修饰甚至骨架的重排,大大丰富了天然产物结构的多样性。因此,阐明天然产物合成过程中氧化还原酶所扮演的角色,对于其后续的成药性研究以及发展新型的生物催化工具具有重要的意义。

图-1、Alchivemycin A的生物合成过程
近期,凯发k8官网戈惠明和谭仁祥课题组阐释了Alchivemycin A(AVM,1)生物过程中的氧化还原次级代谢网络,包括AVM关键药效团的形成及自抗性研究。

AVM是日本科学家从植物内生放线菌Streptomyces sp. TP-A0867中分离得到的复杂多环聚酮化合物,具有强劲的抗菌活性。AVM具有罕见的2H-四氢-4,6-二氧代-1,2-恶嗪(TDO)环系统,以及包括两个环氧环在内的众多氧化后修饰。然而,至今AVM生物合成的氧化还原后修饰过程特别是独特恶嗪环的形成过程以及其抗菌机制,未有报道。
在这项研究中,作者阐明了一种涉及六种氧化还原酶催化AVM形成的氧化还原代谢网络。作者通过体内基因敲除,体外生化分析和一锅酶法合成来表征了这种复杂的氧化还原网络。突变株中得到的前体化合物2可以相对无序的经FAD依赖的单加氧酶(AvmO1,AvmO2,AvmO3),F420依赖的氧化还原酶(AvmR),α-KG/Fe2+依赖的双加氧酶(AvmO4)以及P450(AvmP)作用,通过12条不同的路径网络化生成AVM(图-1,2,3)。首先,2可以经过AvmR,AvmO2,AvmO3作用分别将C25位的羰基还原为羟基,以及形成C14-C15位和C11-C12位的环氧环,这3个酶的催化并没有先后之分,但最终都汇聚生成化合物9。中间体9随后依次经AvmP(C24位羟基化)、AvmO1(TDO环形成)和AvmO4(C22位羟基化)作用形成终产物AVM(图-1,红色箭头,路径a)。另外,化合物10也可以经AvmP、AvmO1、AvmO4和AvmO3催化得到AVM(图-1,蓝色箭头,路径b),其中路径b中的8,10,15又可以通过AvmO3汇聚到路径a中,最终以一种氧化还原网络的形式生成AVM(图-1)。最后,作者以化合物2为底物,在体外用6个酶重构了AVM的生成(图-3F)。

图-2、S. sp. TPA0867野生型菌株及氧化还原酶编码基因突变株发酵HPLC图分析
更重要的是,作者发现并阐明了FAD依赖的单加氧酶AvmO1催化酰胺键上C-N间的插氧形成AVM中的TDO环,这与Bayer-Villiger单加氧酶(BVMOs)催化的反应十分相似,并且氧标记实验也证实AvmO1催化的反应过程可能与Bayer-Villiger氧化一致(图-3)。但之前报道的BVMO未见有C-N间插氧的报道,这可能代表了黄素氧化酶一种前所未有的催化功能。

图-3、AVM生物合成过程中功能酶的体外研究,A)AvmO4的体外酶催化分析,B)AvmO1 、AvmO2 、AvmO3、 AvmP 和AvmR的体外酶催化分析,C)AvmO1与BVMOs的进化树分析,D)AvmO1催化反应的18O标记,E)AvmO1可能的催化机理,F)以2为底物一锅法合成1
在随后的活性测试中作者还发现,TDO环对于AVM的抗菌活性至关重要,在将编码负责RNA聚合酶β亚基合成的基因avmK导入AVM敏感菌株Streptomyces sp. 120454后发现,AVM对其生长不再产生影响(图-4)。这表明AVM可以靶向性与RNA聚合酶的β亚基相互作用产生抗菌活性,而微生物自身通过靶标修饰赋予AVM自抗性。这反映了一种微生物在应对环境变化与生存竞争过程中有意思的进化过程,首先通过自身酶修饰产生含TDO环的抑菌化合物,抑制其他微生物生长以保证自身获得更充足的生存空间,然后将自身的RNA聚合酶β亚基(即抑菌分子的作用靶点)突变产生自抗性而不受影响。
图-4、AVM及类似物的活性及自抗性研究,A,B)AVM及类似物对Micrococcus luteus的作用效果,C,D,E)AVM对S. sp. 120454野生型及导入不同基因后菌株的作用效果
综上,本论文通过一系列体内,体外生化实验阐明了AVM的生物合成过程,其中包括一个前所未有的FAD依赖的单加氧酶催化的C-N间的插氧,且其介导形成的TDO环是AVM发挥抗菌作用的关键药效基团。同时定位到了AVM抗菌的作用靶点RNA聚合酶β亚基及其自抗性基因avmK。本文的发现扩展了黄素氧化酶的功能范围,并为基于AVM的抗菌化合物和生物催化剂开发提供了更多见解。
相关工作“Redox Modifications in the Biosynthesis of Alchivemycin A Enable the Formation of Its Key Pharmacophore”发表在J. Am. Chem. Soc.上。凯发k8官网博士研究生朱宏杰为文章第一作者,戈惠明教授和谭仁祥教授为文章共同通讯作者,凯发k8官网医药生物技术国家重点实验室为第一单位。
该项研究工作得到国家杰出青年基金、国家重点研发计划等项目的资助。
文章链接:https://pubs.acs.org/doi/10.1021/jacs.1c00516